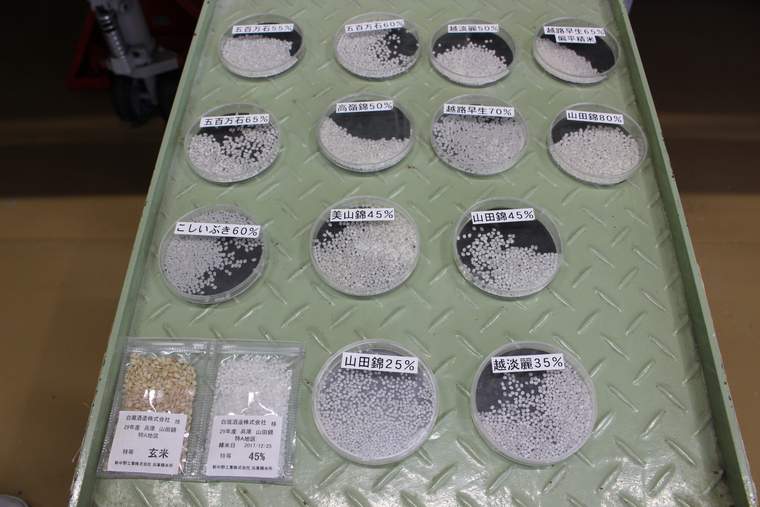
白瀧酒造の酒蔵見学

日本屈指の米どころ、新潟。中でも越後湯沢駅周辺は、日本酒にまつわるスポットが豊富で、酒蔵見学で楽しく学びながら試飲をしたり、酒造の技術を活かしたスイーツや化粧品に出会ったりと、その魅力をたっぷり味わえます。
東京からは上越新幹線で約1時間20分とアクセスも便利な越後湯沢の街を散策しながら、「のんべえ」な旅を満喫しましょう。すべて駅から徒歩で行けるので、温泉やスキー、アウトドア、他の酒蔵めぐりで訪れた翌日に立ち寄るにもぴったりです!
江戸時代から続く老舗酒蔵「白瀧酒造」で、見学・試飲
まずは、越後湯沢駅より徒歩5分ほどの距離にある「白瀧酒造(しらたきしゅぞう)」の酒蔵見学へ。創業は安政2年(1855年)の老舗酒造で、全国的にも有名な日本酒「上善如水(じょうぜんみずのごとし)」の販売元です。

とてもモダンで入りやすい外観。入り口に飾られた「杉玉」は、昔ながらの新酒完成の合図です。
白瀧酒造の看板商品「上善如水 純米吟醸」 看板商品の名の通り、白瀧酒造では「水」にこだわったお酒造りをしています。その長い歴史に酒造りの基礎を学びつつも、最新の機材設備の中で日本酒が造られる、温故知新の精神が詰まった酒蔵さんです。
日頃、日本酒造りに励む蔵人さんに解説いただきながら、見学ツアーはスタートします。前営業日までの完全予約制ですので、公式Webサイトから必ず予約をしておきましょう。
もっと日本酒が好きになる、こだわりの詰まった蔵見学
まずは、日本酒の原料となるお米から。
日本酒を選ぶ際、磨きの歩合を参考にする方も多いかと思いますが、実際に磨きを入れたお米を見学することができます。25%まで削られたお米は角がなく、削る前と比べてかなり小さな粒に。磨けば磨くほど雑味のない香り高い日本酒になるといいますが、粒が小さい分、水分量や温度の管理が難しいそう。とても繊細な作業で造られていることを実感します。

こちらは、アルコールを発酵させる「もろみ造り」と呼ばれる工程。タンクを上からのぞき込むと、白濁した液体から炭酸ガスがふつふつと発生しており、日本酒が出来上がろうとする様子を間近に見ることができます。

大きな屋外タンクには、完成した原酒が低温貯蔵されています。越後湯沢は豪雪地帯のため、冬には除雪作業に手間がかかるそう。雪国だからこその苦労が学べます。

お米やもろみ、貯蔵のことなどを一つ一つ丁寧に説明してくださる蔵人さんの話に耳を傾け、最後はしぼりたての新酒とご対面。たくさんの工程を経て私たちの手元に届いていることを実感したとき、あらためて日本酒の奥深さに魅了されることでしょう。
見学後は、お待ちかねの試飲!

約1時間かけて見学を終えたら、併設のショールームで試飲ができます。試飲リストには、10種類以上の銘柄が!
看板商品「上善如水」シリーズや、酒蔵限定の原酒などを試すことができます。中でも「上善如水スパークリング」は、華やかな香り漂うすっきりとした味わいで女性人気が高いのだとか。
白瀧酒造「上善如水スパークリング」 パッケージデザインや、ボトル形状へのこだわりも、女性人気の秘訣。白瀧酒造では、女性でも手に取りやすい商品の開発に取り組んでいるそうです。
なお、酒蔵見学をしなくても無料で試飲ができるので、気軽にショールームへ足を運んでみてくださいね。
お土産には、かわいい日本酒とコスメを

試飲後は、気に入ったお酒をお土産に購入しましょう。

日本酒とは思えないほど、ゆるくてポップなパッケージのこちらは「純米吟醸 マイタイム」(300ml・756円)。 新潟を拠点に活躍するイラストレーター・神田亜美さんがラベルを描きおろしており、思わずパケ買いしてしまいそうなかわいさ! もちろんその味は老舗酒造の折り紙つきで、飲みやすいフレッシュな香りが特長です。
酒蔵見学をしたあとだと、製品への思いもひとしお。ぜひ、お気に入りの1本を見つけてみてください。

白瀧酒造では、自社開発のスキンケアシリーズも販売。
日本酒由来の「コメ発酵液(保湿)」や、独自開発の「酒粕発酵エキス(保湿)」を主成分とした、高保湿の化粧品がそろいます。テスターも用意されているので、気になる商品を実際に試すことができますよ。

最近では新ブランド「MISHU(ミシュ)」のヘアケア&ボディーケアアイテムが人気とのこと。「コメ発酵液(保湿)」を主な成分とし、ヘアシャンプー、ヘアコンディショナー、ボディーソープの各アイテムに合わせてローマカミツレ花油、レモン果皮油、セイヨウハッカ油などのエッセンシャルオイルを配合。爽やかな香りと酒蔵ならではの保湿成分が、バスタイムをより豊かな時間にしてくれます。
白瀧酒造株式会社
- 住所
- 新潟県南魚沼郡湯沢町大字湯沢2640
- 電話
- 0120-85-8520
- 酒蔵見学
- 前営業日までの完全予約制(10:00~/13:00~の1日2回開催)
※試飲・販売は土日祝および会社休日を除く、10:00~12:00(最終受付11:30)、13:00~15:00(最終受付14:30)
日本酒とのペアリングを楽しむ「魚沼キュイジーヌ」ランチ
ランチは、越後湯沢駅西口の目の前にある「むらんごっつぉ」がおすすめ。

宿泊施設の「越後湯沢 HATAGO井仙」2階にあるレストランで、厳選された日本酒とともに、地元の食材をたっぷり使った「魚沼キュイジーヌ料理」をいただきましょう。

雪国の食文化を伝える料理は、早春・新緑・夏・秋・冬の年に5回メニューが替わります。ランチのメニューは、ランチコースまたはランチセット。今回は、メインディッシュがお好みで選べる人気のコース「ウオヌマコース」(2,500円・税別)で、早春のメニューをいただきます。コースですが、当日のオーダーでも注文は可能です。

お料理に合わせた日本酒が豊富に用意されているので、コースと一緒にいろいろなお酒をグループでシェアしながら楽しみましょう。 食前酒には「瓶内二次発酵酒 あわ 八海山」(ミニボトル360ml、2,650円・税別)を。シャンパンと同じ製法で造られたという日本酒で、きめ細やかな泡と爽やかな口当たりが、乾杯にぴったりです。


お料理は、日本海で獲れたハタハタや春の訪れを感じる菜の花、雪の中で甘みが増した春キャベツなど、季節の恵みを盛り合わせたアミューズからスタート。刻み野菜をたっぷりふりかけた鮮魚の前菜が続きます。

メインは魚または肉料理をお好みでチョイスできます。写真は、お魚料理。新鮮なスズキにレモンをかけてさっぱりと、山菜のソースとともに堪能しました。

メインの魚料理にも、日本酒を。南魚沼市にある老舗蔵元「青木酒造」とコラボレートして作られた「無濾過生原酒 宿酒仙七」(グラス、600円・税別)がよく合います。辛口淡麗の味わいが、あっさりとした白身魚を引き立ててくれます。
ワインのようなグラスは、フランス・シャンパーニュ地方のグラスメーカーである「レーマン社」が「八海山」と共同開発したもので、ダイレクトに日本酒の風味が伝わるよう、グラスを傾ける角度まで計算されているのだそう。一層豊かな味わいを楽しめます。


ほかにも、店内入口に構える大きな釜でふっくらつやつやに炊き上げた魚沼産コシヒカリを始め、雪下で寝かせることでアクが抜けて甘みが引き立つニンジンのデザートなど、ここでしか味わえない美食の数々が運ばれてきます。


魚沼の旬の食材で作られた美しいお料理を、日本酒とのペアリングで楽しめるという、酒どころ・新潟ならではのお食事を心ゆくまで楽しんでみてください。
むらんごっつぉ
- 住所
- 新潟県南魚沼郡湯沢町大字湯沢2455 HATAGO井仙2F
- 電話
- 025-784-3361
- 営業時間
- ランチ: 11:30~14:30(LO 14:00)
ディナー: 17:50~、19:30~の2部制(LO 20:00)
- 定休日
- 水曜
他では買えない限定酒も!?地酒専門店でお土産選び
ランチを堪能したら、越後湯沢駅の東口前、むらんごっつぉからだと徒歩約7分の「タカハシヤ」でゆっくりお土産を選びましょう。こちらのお店では、約20カ所の蔵元から仕入れる日本酒を数多く取り揃えています。


タカハシヤを含む越後湯沢内3店舗でしか買えない緑色ボトルの限定酒「上善如水」(1,944円)や、甘めで飲みやすい純米酒「魚沼清酒 豊醇無盡(ほうじゅんむじん) たかちよ」(1,389円)のほか、季節によって入れ替わる限定品もあるそうです。

ストレートな地酒だけでなく、日本酒をベースにしたリキュールも女性におすすめ。とくに「柚子ノムネ」(432円)は、豊かな柚子の風味があり、人気の商品です。純米酒を主体としたノーマルタイプの「ノムネ」(432円)には、お好みのフルーツをしぼり入れることでオリジナルの味を楽しめます。

お酒に合うおつまみも豊富。 地元産トウガラシを塩漬けにして雪の上でアクを抜き、麹や柚子などと混ぜて発酵させた上越地方に伝わる香辛調味料「かんずり」(540円)、さらにそれを酒盗とコラボさせた「かんずり酒盗」(540円)など、珍しいアテもおすすめです。日本酒と合わせて選んでみてくださいね。
タカハシヤ
- 住所
- 新潟県南魚沼郡湯沢町湯沢2-1
- 電話
- 025-784-2115
- 営業時間
- 9:00~19:00
- 定休日
- 木曜
※現在改装中につき自店倉庫にて仮店舗営業中。営業時間9:00~18:00 ※2019年8月上旬までの予定
帰りの新幹線までは、駅ナカの「ぽんしゅ館」を楽しもう
最後に越後湯沢の駅ナカで、帰りの新幹線が来る直前まで日本酒を堪能しましょう。お酒好きには有名な「越後のお酒ミュージアム ぽんしゅ館」です。

ここには、ワンコインで新潟の銘酒をテイスティングできるコーナーから、カフェ、酒風呂まで、酒どころ・新潟の魅力が詰まった施設が並んでいます。
100種類以上から選んで唎酒!

入口付近にある「唎酒(ききざけ)番所」は、唎酒マシーン。壁一面にずらりと並ぶ日本酒ラベルは圧巻です! 500円で最大5杯分の日本酒がテイスティングできるという手軽さも魅力。まずは受付で支払いを済ませ、おちょことメダル5枚を受け取り店内へ進みましょう。

ワイン3種、焼酎3種、梅酒6種を含め、テイスティングできるお酒の種類は100種以上にものぼります。新潟にある酒蔵およそ89カ所の日本酒はすべて網羅しているのだそう。

希少価値の高い日本酒や、季節で入れ替わる銘柄など、とにかくバラエティー豊かです。先ほど見学に伺った、白瀧酒造「上善如水」シリーズの、ここでしか飲めない限定酒も。通常品と比べ、リンゴのような爽やかさと甘い香りがあり、コクを感じる味わいです。

銘柄によって必要なメダル枚数が異なり、おちょこをセットしてメダルを投入するとお酒が注がれます。ぽんしゅ館のロゴである「ポ」があしらわれたデザインもおしゃれで、おいしくいただけそうです。

たくさんありすぎて迷ってしまう、というときには、「日本酒度」を参考に飲みたいお酒を探しましょう。この数字がプラスであるほど辛く、マイナスになるほど甘口になります。

日本酒のおともに、種類豊富な塩のテイスティングがなんと無料で用意されています!
その昔、塩を舐めながら日本酒が飲まれていたことから全国各地の日本酒に合う塩が集められており、一緒に味わえばお酒の甘さと辛さが一層引き立ちます。

生きゅうりは、100円とお手頃価格。お酒の味が引き立つシンプルなおつまみが嬉しいですね。
唎酒番所
- 営業時間
- 9:00~19:00(LO18:45)※シーズンにより変動あり
米麹のスイーツでひと息
日本酒をいただいたら、併設のカフェ「糀(こうじ)らって」でブレイクタイム。

米麹を使用したほんのり甘いラテやドリンク、雪室貯蔵で豆を寝かせることでまろやかな味になったコーヒーなど、酒どころ・新潟の知恵を活かしたカフェメニューが楽しめます。

なかでも、「糀ソフトクリーム」(380円)は絶品! 濃厚なコクと甘さが口の中いっぱいに広がって、少し溶けた頃には麹の風味がより強く感じられるようになり、食べているうち味わいにも変化が生まれます。

購入した商品はラウンジのような落ち着いた空間でいただくもよし、手軽にテイクアウトするもよし。冷たくてさっぱりとしたソフトクリームは唎酒のあとのお口直しにもぴったりです。
糀らって
- 営業時間
- 9:00~19:00(LO18:45)※シーズンにより変動あり
これぞ変化球!日本酒入り風呂
「酒風呂 湯の沢」では、なんと日本酒のお風呂に入ることも! 旅の疲れを癒しましょう。

天然の温泉に、魚沼市の「玉川酒蔵」へ特別に依頼しているお風呂専用の日本酒を直接投入しているそうで、血行促進や美肌効果が期待できるのだとか。ほんのりお酒の香りが漂いますが、匂いで酔っぱらうことなく未就学児でも入浴できます。


貸しタオル付きでスキンケア用品も完備しているから手ぶらで訪れてもOK。スキーや登山などのレジャー帰りに利用するゲストが多く、地元の方々にも親しまれています。旅の締めくくりは、こちらの温泉で疲れを癒してみてはいかがでしょうか。
酒風呂 湯の沢
- 営業時間
- 10:30~18:30(LO18:00)※シーズンにより変動あり
- 入浴料金
- 大人(中学生以上)800円、小学生400円
越後のお酒ミュージアム ぽんしゅ館
- 住所
- 新潟県南魚沼郡湯沢町湯沢2427-3(JR越後湯沢駅構内)
- 電話
- 025-784-3758
- 営業時間
- 9:00~19:00 ※シーズンにより変動あり
- 定休日
- 無休
日本酒にまつわるスポットが豊富な越後湯沢駅周辺。飲むことはもちろん、スキンケアにスイーツに温泉に、バリエーションに富んだ日本酒の形に出会えるはず。米どころ・新潟ならではの日本酒体験ができる越後湯沢を、ぜひ訪れてみてください。
取材・写真・文/堀江ゆき
※掲載内容は公開時点のものです。ご利用時と異なることがありますのでご了承ください。
※表示価格は、税別の表記がないものは全て税込です。

